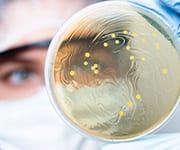
There are differences between prebiotics and postbiotics

Life Extension Magazine®
Scientists investigating the gut microbiome in people who live to be at least 100 years old have made an astonishing discovery:
Healthy centenarians
have a makeup of gut
bacteria with signatures
similar to that of
younger people.1
A combination of three probiotics plus a postbiotic can help shift the gut microbiome toward a similar youthful state supporting healthy aging.
In a clinical study of elderly adults, taking a blend of two of these probiotics:
- Improved the microbiome by increasing beneficial bacteria and reducing harmful strains,2
- Decreased markers of chronic inflammation,2,3 and
- Improved nutritional status.3
A third probiotic4,5 improved cholesterol levels in clinical studies, supporting cardiovascular health.
In animal model studies, an additional heat-treated postbiotic improved the gut microbiome,6,7 and in one study, it was associated with increased lifespan.7
These new data sets add to what is already known about the importance of maintaining a healthy microbiome.
The Microbiome-Aging Link
Growing evidence demonstrates the key role the gut microbiome plays in health as we age.8-10
An imbalance of gut microorganisms has been described by scientists as one of the "hallmarks of aging."11
Age-related dysbiosis, which is an imbalance of the gut microbiome, can trigger harmful inflammation and chronic diseases,12-14 which are potential contributors to reduced longevity.14,15
Beneficial gut bacteria, on the other hand, may help support a healthy lifespan.16-18
Scientists have documented the potential for probiotics, which are live microorganisms taken orally, to promote a healthier gut microbiome.19-22 They have long been used to improve specific health conditions.20,23-25
But researchers have also found that certain probiotic strains help promote healthier overall aging. This includes combating negative age-related changes in the gut microbiome that could interfere with reaching age 100 or above.
Gut Microbiomes of Centenarians
Scientists have identified critical differences between the gut microbiomes of frail, aging individuals and healthy individuals aged 100 years and older.
Over time, the majority of people develop an imbalance or negative changes in the composition of their gut bacteria. This change in the microbiome can result in:
- Inflammation, which can lead to frailty, metabolic disease, and neurodegeneration,26 and
- Immune Senescence, age-related deterioration of the immune system.27,28
By contrast, healthy guts of thriving centenarians include certain characteristics:
- Higher levels of beneficial bacteria, such as Akkermansia, Bifidobacterium, and Lactobacillus,1,29,30
- Lower levels of potentially inflammatory bacteria, such as Proteobacteria,1,31
- Greater levels of beneficial short-chain fatty acids produced by gut bacteria,30-32 and
- Fewer pro-inflammatory cytokines (signaling molecules).1,29,31
Mounting evidence suggests that targeting age-related gut imbalance and restoring healthy bacteria may promote longer healthspan and lifespan by mitigating systemic low-grade inflammation and immune senescence—two key contributors to aging.28
In a major advance, scientists have identified three probiotics and a postbiotic that may help rebalance aging, dysbiotic microbiomes to more closely resemble the gut microbiomes of healthy centenarians.
Healthy Aging Strains
Scientists isolated two probiotic strains from healthy elderly individuals:33
- Lactobacillus rhamnosus IMC 501® and
- Lactobacillus paracasei IMC 502®
In human studies, these strains were shown to be tolerant to the gut’s acidic environment.33,34
When combined, both strains have been shown to positively impact bowel regularity,34 reduce inflammatory markers,2,3 and inhibit potentially harmful microorganisms such as Candida albicans.33
In a randomized, controlled clinical trial, 97 healthy individuals with an average age of 81 took either a placebo or 5 billion CFU (colony forming units) of a blend of these two strains.2,3
After 24 weeks, researchers found that the treatment group had:2,3
- Improvement in growth of other probiotic strains associated with health and longevity such as Akkermansia, Bifidobacterium, and Lactobacillus,
- Reduced levels in the Proteobacteria phylum, known to contain harmful bacteria,
- Increased beneficial short-chain fatty acids, including butyric acid, which may have anti-inflammatory, anticancer, and gut-healing effects,35
- Decreased inflammatory factors,
- Lower hs-CRP (high-sensitivity C-reactive protein), a measure of chronic blood vessel inflammation, and
- Improved nutritional status and reduced malnutrition risk, based on standardized nutritional assessments.
What You Need To Know
Probiotics for Healthy Aging
- Certain probiotics have been shown to support overall healthy aging.
- In a clinical study, a blend of two probiotic strains isolated from healthy elderly individuals, Lactobacillus rhamnosus IMC 501® and Lactobacillus paracasei IMC 502®, improved the makeup of the gut microbiome and other factors associated with a healthy lifespan.
- In clinical trials, the probiotic Lactobacillus plantarum ECGC 13110402 improved cholesterol levels, which supports cardiovascular health.
- A postbiotic form of Lactobacillus paracasei D3-5 extended lifespan and improved physical and cognitive function in animal models.
- Taken together, these ingredients may help shift the gut microbiome toward a more youthful state for better health.
Probiotic for Cholesterol Support
Lowering cholesterol is one of the key methods to support cardiovascular and overall health. After examining over 4,000 candidates, scientists identified a probiotic with this benefit: Lactobacillus plantarum ECGC 13110402.
In two randomized, double-blind clinical trials, volunteers took either a placebo or 4 billion CFU of Lactobacillus plantarum ECGC 13110402 daily.4,5
In the first trial, 46 participants had an average age of 52 and cholesterol in the normal-to-high range. After 12 weeks, treated subjects had the following modest results:4
- 8% decrease in total cholesterol,
- 5% increase in HDL ("good") cholesterol in those aged 60 and older,
- 3% increase in HDL cholesterol on average, and
- Lower-trending LDL ("bad") cholesterol levels.
The second trial’s participants were aged 35 to 70 and had high cholesterol levels. After just six weeks, treated subjects had the following more robust results:5
- 22% decrease in total cholesterol,
- 13% lower non-HDL cholesterol,
- 12% lower LDL cholesterol, and
- 8% lower levels of ApoB (apolipoprotein B). ApoB promotes penetration of atherogenic lipids into the endothelium.
Longer Animal Lifespan
Substances known as postbiotics are also associated with potential health improvements.6,7,36
Postbiotics are heat-treated, non-living micro- organisms.37
In an animal study, a blend of microorganisms containing Lactobacillus paracasei D3-5, isolated from infant fecal samples, was given to healthy mice.6
It modulated the gut microbiome in mice, increasing short-chain fatty acid production, particularly beneficial propionate and butyrate.6
In another study, a postbiotic created from heat-treated Lactobacillus paracasei D3-5 extended lifespan and preserved physical function in roundworms.7
In elderly mice, the Lactobacillus paracasei D3-5 postbiotic:7
- Improved physical and cognitive function,
- Prevented high-fat-diet-induced metabolic dysfunction,
- Decreased leaky gut, and
- Lowered inflammation.
Combining this postbiotic with probiotics supports a balanced microbiome by promoting beneficial bacteria and suppressing harmful ones, thereby reducing detrimental factors and promoting healthy aging.
Probiotics and Postbiotics: What’s the Difference?
Probiotics are live microorganisms, such as bacteria and yeast, that provide health benefits when consumed in adequate amounts. They can be consumed through food, beverages, or supplements. The health benefits of probiotics are strain-specific, meaning different strains exert distinct health effects.38
Postbiotics—post- (after) and biotic (life)are formulations containing non-living microorganisms, and/or their components, that confer health benefits to the host. Microbial inactivation is typically achieved through methods such as heat, ultraviolet (UV) light, or sonication, which may also break cells into structural components like bacterial cell walls. Additionally, postbiotics may include metabolic byproducts of microbial growth, such as lactic acid. Like prebiotics, postbiotics can exert beneficial effects beyond the gut, including on the vaginal and skin microbiomes.39
Summary
Humans aged 100 years or more share certain gut bacteria characteristics with much younger people, motivating scientists to identify strains that may promote healthy aging.
Researchers isolated two Lactobacilli strains from healthy, elderly humans. In clinical studies, a blend of these probiotics improved the microbiome and other factors associated with health and longevity.
A third Lactobacillus strain was clinically demonstrated to lower cholesterol, a key factor in heart health and healthy aging.
A postbiotic form of another Lactobacillus strain extended lifespan and improved physical and cognitive function in animal models.
Taken together, these four microbiome constituents may support optimal health well into advanced age.
If you have any questions on the scientific content of this article, please call a Life Extension Wellness Specialist at 1-866-864-3027.
References
- Pang S, Chen X, Lu Z, et al. Longevity of centenarians is reflected by the gut microbiome with youth-associated signatures. Nat Aging. 2023 Apr;3(4):436-49.
- Salvesi C, Silvi S, Fiorini D, et al. Impact of a probiotic diet on well-being of healthy senior: THE PROBIOSENIOR PROJECT. J Appl Microbiol. 2022 Nov;133(5):2941-53.
- Salvesi C, Silvi S, Fiorini D, et al. Six-Month Synbio(R) Administration Affects Nutritional and Inflammatory Parameters of Older Adults Included in the PROBIOSENIOR Project. Microorganisms. 2023 Mar 21;11(3):801.
- Costabile A, Buttarazzi I, Kolida S, et al. An in vivo assessment of the cholesterol-lowering efficacy of Lactobacillus plantarum ECGC 13110402 in normal to mildly hypercholesterolaemic adults. PLoS One. 2017;12(12):e0187964.
- Keleszade E, Kolida S, Costabile A. The cholesterol lowering efficacy of Lactobacillus plantarum ECGC 13110402 in hypercholesterolemic adults: a double-blind, randomized, placebo controlled, pilot human intervention study. Journal of Functional Foods. 2022 2022/02/01/;89:104939.
- Nagpal R, Wang S, Ahmadi S, et al. Human-origin probiotic cocktail increases short-chain fatty acid production via modulation of mice and human gut microbiome. Sci Rep. 2018 Aug 23;8(1):12649.
- Wang S, Ahmadi S, Nagpal R, et al. Lipoteichoic acid from the cell wall of a heat killed Lactobacillus paracasei D3-5 ameliorates aging-related leaky gut, inflammation and improves physical and cognitive functions: from C. elegans to mice. Geroscience. 2020 Feb;42(1):333-52.
- Badal VD, Vaccariello ED, Murray ER, et al. The Gut Microbiome, Aging, and Longevity: A Systematic Review. Nutrients. 2020 Dec 7;12(12).
- Conway J, N AD. Ageing of the gut microbiome: Potential influences on immune senescence and inflammageing. Ageing Res Rev. 2021 Jul;68:101323.
- Ling Z, Liu X, Cheng Y, et al. Gut microbiota and aging. Crit Rev Food Sci Nutr. 2022;62(13):3509-34.
- Lopez-Otin C, Blasco MA, Partridge L, et al. Hallmarks of aging: An expanding universe. Cell. 2023 Jan 19;186(2):243-78.
- Biragyn A, Ferrucci L. Gut dysbiosis: a potential link between increased cancer risk in ageing and inflammaging. Lancet Oncol. 2018 Jun;19(6):e295-e304.
- Thevaranjan N, Puchta A, Schulz C, et al. Age-Associated Microbial Dysbiosis Promotes Intestinal Permeability, Systemic Inflammation, and Macrophage Dysfunction. Cell Host Microbe. 2017 Apr 12;21(4):455-66 e4.
- Shintouo CM, Mets T, Beckwee D, et al. Is inflammageing influenced by the microbiota in the aged gut? A systematic review. Exp Gerontol. 2020 Nov;141:111079.
- Kim S, Jazwinski SM. The Gut Microbiota and Healthy Aging: A Mini-Review. Gerontology. 2018;64(6):513-20.
- He D, Liu L, Zhang Z, et al. Association between gut microbiota and longevity: a genetic correlation and mendelian randomization study. BMC Microbiol. 2022 Dec 13;22(1):302.
- Clemente JC, Ursell LK, Parfrey LW, et al. The impact of the gut microbiota on human health: an integrative view. Cell. 2012 Mar 16;148(6):1258-70.
- Bana B, Cabreiro F. The Microbiome and Aging. Annu Rev Genet. 2019 Dec 3;53:239-61.
- Ebel B, Lemetais G, Beney L, et al. Impact of probiotics on risk factors for cardiovascular diseases. A review. Crit Rev Food Sci Nutr. 2014;54(2):175-89.
- Su GL, Ko CW, Bercik P, et al. AGA Clinical Practice Guidelines on the Role of Probiotics in the Management of Gastrointestinal Disorders. Gastroenterology. 2020 Aug;159(2):697-705.
- Chandrasekaran P, Weiskirchen S, Weiskirchen R. Effects of Probiotics on Gut Microbiota: An Overview. Int J Mol Sci. 2024 May 30;25(11).
- Sanchez MC, Herraiz A, Tigre S, et al. Evidence of the Beneficial Impact of Three Probiotic-Based Food Supplements on the Composition and Metabolic Activity of the Intestinal Microbiota in Healthy Individuals: An Ex Vivo Study. Nutrients. 2023 Dec 12;15(24).
- Goldin BR, Gorbach SL. Clinical indications for probiotics: an overview. Clin Infect Dis. 2008 Feb 1;46 Suppl 2:S96-100; discussion S44-51.
- Williams NT. Probiotics. Am J Health Syst Pharm. 2010 Mar 15;67(6): 449-58.
- Coffey MJ, Garg M, Homaira N, et al. Probiotics for people with cystic fibrosis. Cochrane Database Syst Rev. 2020 Jan 22;1(1):CD012949.
- Biagi E, Franceschi C, Rampelli S, et al. Gut Microbiota and Extreme Longevity. Curr Biol. 2016 Jun 6;26(11):1480-5.
- Ragonnaud E, Biragyn A. Gut microbiota as the key controllers of "healthy" aging of elderly people. Immun Ageing. 2021 Jan 5;18(1):2.
- Bosco N, Noti M. The aging gut microbiome and its impact on host immunity. Genes Immun. 2021 Oct;22(5-6):289-303.
- Zeng SY, Liu YF, Liu JH, et al. Potential Effects of Akkermansia Muciniphila in Aging and Aging-Related Diseases: Current Evidence and Perspectives. Aging Dis. 2023 Dec 1;14(6):2015-27.
- Ai X, Liu Y, Shi J, et al. Structural characteristics of gut microbiota in longevity from Changshou town, Hubei, China. Appl Microbiol Biotechnol. 2024 Apr 15;108(1):300.
- Wang J, Qie J, Zhu D, et al. The landscape in the gut microbiome of long-lived families reveals new insights on longevity and aging - relevant neural and immune function. Gut Microbes. 2022 Jan-Dec;14(1):2107288.
- Singh H, Torralba MG, Moncera KJ, et al. Gastro-intestinal and oral microbiome signatures associated with healthy aging. Geroscience. 2019 Dec;41(6):907-21.
- Verdenelli MC, Ghelfi F, Silvi S, et al. Probiotic properties of Lactobacillus rhamnosus and Lactobacillus paracasei isolated from human faeces. Eur J Nutr. 2009 Sep;48(6):355-63.
- Verdenelli MC, Silvi S, Cecchini C, et al. Influence of a combination of two potential probiotic strains, Lactobacillus rhamnosus IMC 501(R) and Lactobacillus paracasei IMC 502(R) on bowel habits of healthy adults. Lett Appl Microbiol. 2011 Jun;52(6):596-602.
- Xiong RG, Zhou DD, Wu SX, et al. Health Benefits and Side Effects of Short-Chain Fatty Acids. Foods. 2022 Sep 15;11(18).
- Ma L, Tu H, Chen T. Postbiotics in Human Health: A Narrative Review. Nutrients. 2023 Jan 6;15(2).
- Salminen S, Collado MC, Endo A, et al. The International Scientific Association of Probiotics and Prebiotics (ISAPP) consensus statement on the definition and scope of postbiotics. Nat Rev Gastroenterol Hepatol. 2021 Sep;18(9):649-67.
- Available at: https://ods.od.nih.gov/factsheets/Probiotics-HealthProfessional/. Accessed April 8, 2025.
- Gurunathan S, Thangaraj P, Kim JH. Postbiotics: Functional Food Materials and Therapeutic Agents for Cancer, Diabetes, and Inflammatory Diseases. Foods. 2023 Dec 26;13(1).